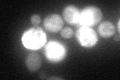
YPR160W
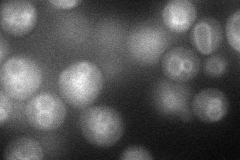
YPR160W
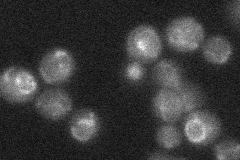
YPR160W

View description
Non-essential glycogen phosphorylase required for the mobilization of glycogen, activity is regulated by cyclic AMP-mediated phosphorylation, expression is regulated by stress-response elements and by the HOG MAP kinase pathway
Localization:
Intensity:
Fold change:
Significance:
-
C’ GFP library in SD
cytosol86.53 -
N' NOP1pr-GFP in SD
vacuole membrane52.3865 -
N' TEF2pr-mCherry in SD

below threshold0 -
N' NATIVEpr-GFP in SD
punctate,nuclear periphery24.0791 -
N' TEF2pr-VC and Cyto-VN in SD

#N/A0 -
C’ GFP library in SD+DTT

punctateN/AN/ANo -
C’ GFP library in SD+H2O2

punctateN/AN/ANo -
C’ GFP library in Starvation Media

cytosol221.242.55Yes -
C’ GFP library on the background of Pup2-DaMP

cytosol -
C’ GFP library on the background of CCT mutant

cytosol109.2511.26245No
